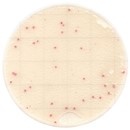
Easy Plate AC-R
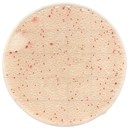
Easy Plate AC-R

Easy Plate AC-R(一般生菌数迅速測定用)
Easy Plate AC-R
- 製造元 :
- キッコーマンバイオケミファ(株)
- 保存条件 :
- 冷蔵 (氷冷輸送)
- 適用法令 :
- 安衛法57条・有害物表示対象物質 労57-2
- GHS :
-
- 構造式
- ラベル
- 荷姿
|
比較
|
製品コード
|
容量
|
価格
|
在庫 / 納期目安
|
|
|---|---|---|---|---|---|
|
|
|
100枚×1
|
|
|
|
|
|
|
100枚×5
|
|
照会 |
|
ドキュメント
- 添付文書
-
- スペクトルデータ
-
- 検査成績書
-
- 校正証明書
-
- 分析チャート
-
特長
酸化還元指示薬により、一般生菌のコロニーを明瞭な赤色に発色させ、検出するフィルム培地です。
Easy Plate AC-Rは、24±1時間で迅速に測定できます。
■明確なコロニーの発色
コロニーが赤く発色するため、食品残渣が多い場合や着色がある場合でも、コロニーの判別、カウントが容易です。
▲検査サンプル:小麦粉
■バチルス属のコロニーが広がりにくい
従来の寒天培地や簡易培地で広がりやすいバチルス属のコロニーが、本製品では広がりにくくなっています。
▲ バチルス属を含む食品
■標準寒天培地と高い相関性
多種多様な食品で、標準寒天培地との高い相関性を確認しております。

製造元情報
別名一覧
- 掲載内容は本記事掲載時点の情報です。仕様変更などにより製品内容と実際のイメージが異なる場合があります。
- 製品規格・包装規格の改訂が行われた場合、画像と実際の製品の仕様が異なる場合があります。
- 掲載されている製品について
- 【試薬】
- 試験・研究の目的のみに使用されるものであり、「医薬品」、「食品」、「家庭用品」などとしては使用できません。
- 試験研究用以外にご使用された場合、いかなる保証も致しかねます。試験研究用以外の用途や原料にご使用希望の場合、弊社営業部門にお問合せください。
- 【医薬品原料】
- 製造専用医薬品及び医薬品添加物などを医薬品等の製造原料として製造業者向けに販売しています。製造専用医薬品(製品名に製造専用の表示があるもの)のご購入には、確認書が必要です。
- 表示している希望納入価格は「本体価格のみ」で消費税等は含まれておりません。
- 表示している希望納入価格は本記事掲載時点の価格です。
Share